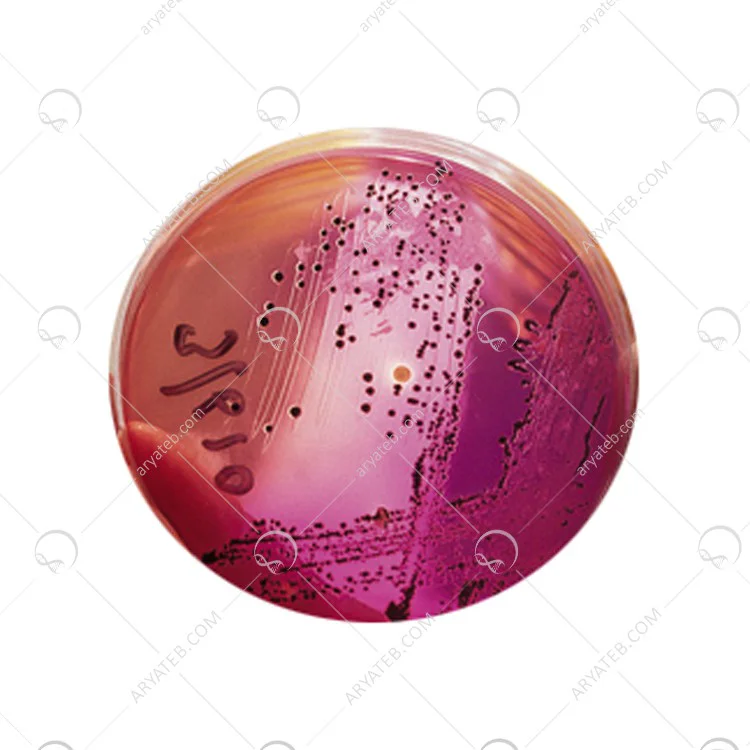

محیط کشت باکتریولوژیک آگار
- دارای ماده کلوئیدیست که تشکیل دهنده ی جزئی از دیواره سلولی میباشد که به کمک جلبک دریایی شکل گرفته است
محیط کشت agar bacteriological
دارای ماده کلوئیدیست که تشکیل دهنده ی جزئی از دیواره سلولی می باشد که به کمک جلبک دریایی شکل گرفته است.
دارای سیگما آلدریچ است ماده کلوئیدی عصاره ایی محلول در آب که گونه ی خاصیست که توسط جلبک قرمز شکل گرفته
فرآورده شده ی این محیط کشت توسط ژل خالص ایجاد شده که موجب ساگازی این محیط و استحکام آن توسط ژل خالص می باشد از این لحاظ بسیار کار آمد می باشد.
درون ماده ی کلوئیدی مقداری کلسیم موجکود استکه اثر وجود منیزیم را کاهش می دهد
این محیط کشت مقاومت بالایی دارد به طوری که قادر به باکتری شناسی جزئی از هیدروکلوئید طبیعی است که درون خود از جلبکی که متشکل از عصاره ی پنجه رودوفیتا می باشد استخراج شده .
این نوع محیط کشت که قادر به باکتری شناسی از نوع خطی می باشد ژل خالص آن متشکل شده هط پلی ساکارید و آگارز ،آگاروپکتین که مانند یک عامل ژل کننده عمل میکند
مناسب کشت های جامدی مثل این نوع کشت است که کاربرد بیولوژیکی را همراه خود دارد.
رشد میکروارگانیسم ها و شفافیت محیط را به همراه خود دارد باکتریولوژیک آمریکایی که از آگار اروپایی ساخته شده در غلظت معین شده باقی میماند تا ژل موجود یا همان آگاراز مقاومت بسیار بالایی برخوردار باشد بیشتر در آب جوش مانند حلال عمل میکند زیرا نوعی آگار درون خود دارد که فرایند تخمیر مفید را به همراه دارد
محیط کشت باکتریولوژیک آگار agar bacteriological
محیط کشت AGAR BACTERIOLOGYCAL ، که به فارسی به محیط کشت باکتریولوژیکی آگار ترجمه می شود. همانطور که می دانید مدل های مختلفی از محیط های در حال رشد وجود دارد که هر کدام فرمول و ساختار گوناگونی دارند و می توان از آنها برای آزمایش در یک محیط استفاده کرد.
.jpg)
محیط کشت باکتریولوژیک آگار چیست
محیط کشت باکتریولوژیکی آگار یک هیدروکلوئید طبیعی است که از جلبک قرمز و همچنین مخلوطی از Gelidium ، Pterocladia و Gracilaria spp تشکیل شده می باشد.
آگار باکتریولوژیکی یک آگار باکتریولوژیکی با مقاومت در برابر یخ بسیار بالا ، شفاف و سازگار با همه محیط های کشت می باشد. این آگار دارای سطوح پایین کلسیم و منیزیم است.
مولکولهای پلی ساکارید آگارز و آگاروپکتین به عنوان یک عامل ژل کننده برای محیط کشت جامد و سایر کاربردهای میکروبیولوژیکی عمل می کنند. مزایای اصلی این آگار خاص عدم وجود بازدارنده های رشد میکروارگانیسم ها و شفافیت عالی در محیط می باشد. آگار آمریکایی قدرت ژله را در مقایسه با آگار باکتریولوژیکی اروپایی که در همان غلظت استفاده می شود افزایش می دهد.
Acumedia از سال 1978 به عنوان یکی از تولید کنندگان برجسته این محیط رشد با کیفیت بالا برای صنایع صنعتی ، دارویی ، بیوتکنولوژی ، ایمنی مواد غذایی و سایر صنایع علمی شناخته شده است.
آگار باکتریولوژیکی یک مجموعه پلی ساکاریدی است که از جلبک های رودوفیزیکی قرمز با حل آگارسیت ها در آب ولرم استخراج می گردد و تقریباً 70٪ آگارز و 30٪ آگاروپکتین دارد. آگارز یک ژل خنثی میباشد که از یک پلیمر خطی متناوب بین واحدهای گالاکتوز و آنهیدروگالاکتوز ساخته شده است. آگاروپکتین یک جزء غیر ژل کننده و غیر ژل کننده می باشد که از واحدهای گالاکتوز متصل به گلیکوزیدها تشکیل شده است.
باکتریولوژیکی سازگار با همه محیط های کشت این محیط کشت را می توان از یک محیط با مقادیر فلزی خیلی مشابه فرموله کرد. این ویژگی به ویژه در مطالعات MIC های ضد میکروبی که تفاوت در محتوای مواد معدنی و فلز ممکن است بر نتایج تأثیر بگذارد مفید می باشد. با توجه به محتوای کمی معدنی و فلزی آگار باکتریولوژیکی ، اکسوئید ، موجب آزاد شدن آزاد مواد ضد میکروبی می شود. بنابراین ، این محیط کشت یک آگار بسیار رضایت بخش برای مطالعات انتشار ضد میکروبی و تست های حساسیت انتشار دیسک است.
آدرس ایمیل شما منتشر نخواهد شد. فیلدهای الزامی علامت گذاری شده اند *